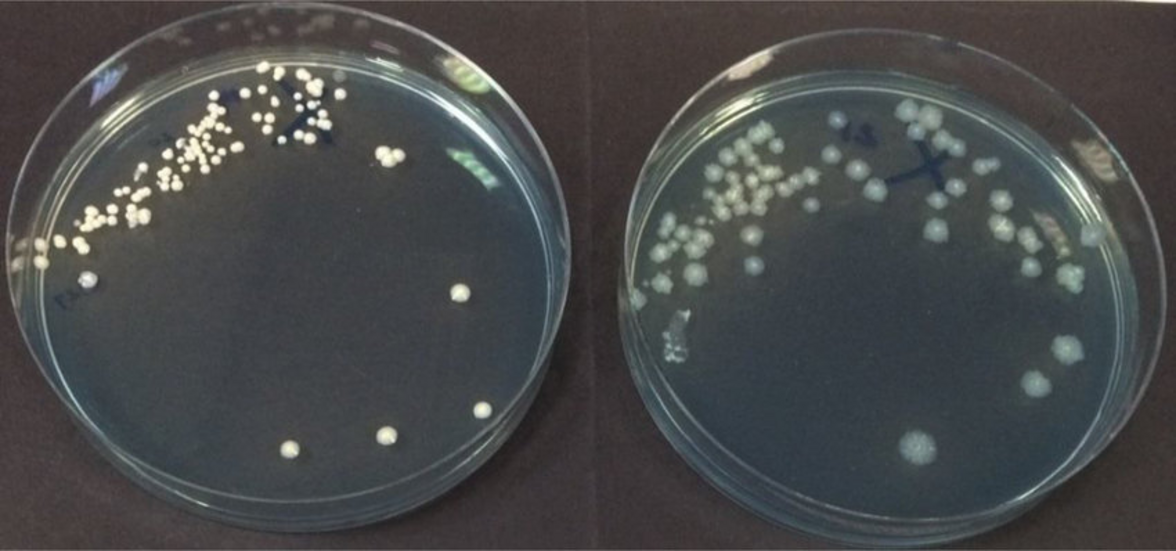
Mycobacterium abscessus; парадокс низкой патогенности и высокой вирулентности

Mycobacterium abscessus - это нетуберкулезная микобактерия, которая является важной причиной прогрессирующей легочной инфекции человека.
Хотя она является реальной причиной легочных и внелегочных заболеваний, ее потенциал относительно невелик. Действительно, легочная инфекция M. abscessus обычно не возникает у иммунокомпетентных людей с нормальными легочными дыхательными путями. С другой стороны, у людей с аномальными дыхательными путями легких, которые в остальном иммунокомпетентны, может развиться прогрессирующая, тяжелая, трудноизлечимая легочная инфекция.
В качестве дополнительного доказательства низкой патогенности этой инфекции, для создания продуктивной инфекции у мышей часто требуются значительные экспериментальные изменения в дизайне исследования; т.е. для создания продуктивной инфекции обычно требуется использование различных типов иммунодефицитных мышей. Отсутствие подходящих моделей мышей, воспроизводящих аномальные дыхательные пути легких, наблюдаемые у человека, еще больше затрудняет эти усилия.
Одним из важных аспектов патогенеза M. abscessus является колонизация аномальных легочных дыхательных путей гликопептидолипидами (GPL) - экспрессирующими варианты гладких колоний, которые способны образовывать биопленки. Спонтанное появление вирулентных вариантов шероховатых колоний, лишенных GPL, приводит к инвазивной инфекции легких и, как следствие, к усилению воспаления легких (Byrd and Lyons, 1999; Howard et al., 2006; Catherinot et al., 2007, 2009; Nessar et al., 2011).
Статьи по данной теме, описывающие образование биопленки M. abscessus в синтетической среде (Belardinelli et al.) и повышение вирулентности мутантов порина наружной мембраны M. abscessus (de Moura et al.), предоставляют доказательства модуляции патогенности M. abscessus селективным давлением в дыхательных путях легких пациентов с муковисцидозом. Эти исследования посвящены эволюционирующей патогенной последовательности легочной инфекции M. abscessus, когда низкопатогенный колонизирующий фенотип легочных дыхательных путей переходит в более вирулентный, провоспалительный фенотип.
Исследование биопленки позволило выяснить генетические и биохимические различия между M. abscessus subsp. abscessus, выращенным в виде биопленки в минимальной синтетической среде, и теми же организмами, выращенными в обогащенной среде, разработанной для имитации условий, в которых M. abscessus может находиться в дыхательных путях легких пациентов с муковисцидозом (синтетическая среда для муковисцидоза-SCFM).
Среди отмеченных различий было значительное присутствие GPLs во внеклеточном матриксе биопленок, сформированных M. abscessus в SCFM, что подчеркивает важную роль, которую эти компоненты клеточной стенки играют в формировании биопленок M. abscessus. Внеклеточная ДНК также присутствует в относительном количестве в матриксе биопленок, сформированных в SCFM, и обеспечивает поддержку установленному использованию рекомбинантной человеческой ДНКазы у пациентов с муковисцидозом.
Эти результаты показывают, что рост биопленки M. abscessus в SCFM является полезным методом для выявления потенциальных детерминант вирулентности, регулируемых в условиях, которые имитируют дыхательные пути пациентов с муковисцидозом. Аналогичным образом, в статье о порине представлены доказательства того, что делеции и перестройки в генах порина серийно отобранных изолятов M. abscessus от пациентов с муковисцидозом происходят в ответ на давление отбора хозяина. В частности, делеция двух из этих пориновых генов, mmpA и mmpB, приводит к усилению репликации нокаутированных мутантов в макрофагах, полученных из костного мозга мышей с нокаутом SCID и GM-CSF, а также в мышиной модели инфекции SCID. Результаты обоих этих исследований подтверждают концепцию о том, что давление отбора хозяина усиливает вирулентность M. abscessus после колонизации дыхательных путей легких.
Одна из гипотез развития легочной инфекции M. abscessus заключается в том, что хроническое воспаление приводит к подавлению иммунного ответа Th1, необходимого для клиренса (Orme and Ordway, 2014). Если это так, то статья, описывающая воздействие руфомицина непосредственно на M. abscessus и иммунный ответ хозяина (Park et al.), предполагает двойную стратегию лечения легочной инфекции M. abscessus с помощью этого препарата. Непосредственно подавляя возбудителя и ослабляя провоспалительный ответ, вызываемый грубыми инвазивными вариантами, этот препарат может действовать новым способом, предотвращая полную реализацию потенциала вирулентности этой бактерии.
Статья, описывающая анализ высвобождения интерферона-гамма (IGRA) (Steindor et al.), демонстрирует потенциальное использование специфического антигена M. abscessus в IGRA, предназначенном для диагностики инфекции M. abscessus. Вопрос о том, что является коррелятом эффективного иммунного ответа на легочную инфекцию M. abscessus, остается открытым. В данном исследовании большинство пациентов составляли больные муковисцидозом и лишь небольшое количество пациентов с бронхоэктазами, не страдающих муковисцидозом. Дополнительные исследования с использованием этого анализа были бы информативны для различения ответа IGRA у пациентов с хронической колонизацией дыхательных путей легких по сравнению с пациентами с инвазивным паренхиматозным заболеванием легких, а также у пациентов, колонизированных/инфицированных гладкими изолятами, экспрессирующими GPL, по сравнению с грубыми изолятами, не содержащими GPL.
Вместе эти статьи являются важным вкладом в изучение M. abscessus и предоставляют доказательства, подтверждающие концепцию, согласно которой M. abscessus обладает низкой патогенностью, пока не сможет колонизировать предпочитаемую нишу в аномальных дыхательных путях легких, что приводит к усилению вирулентности, инвазивной легочной инфекции и избеганию иммунных защитных механизмов хозяина.